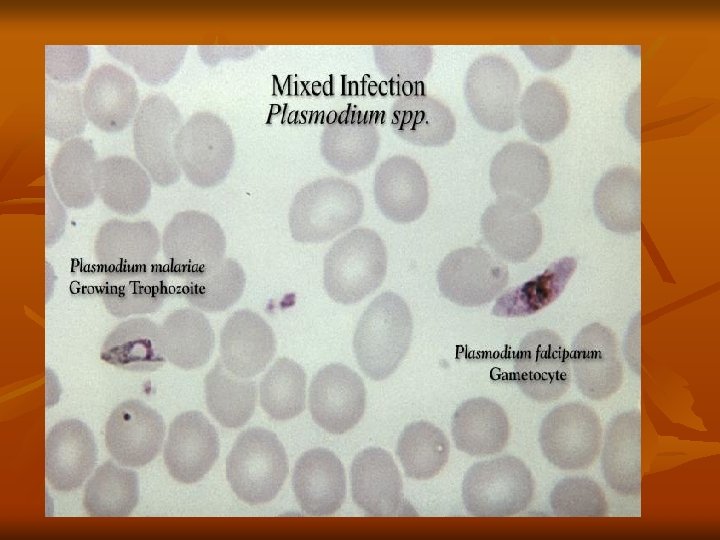

Class Sporozoa Protozoan parasites characterized by the production


Class Sporozoa -Protozoan parasites characterized by the production of spore-like oocysts containing sporozoites were known as sporozoa. -Intracellular parasites, at least during part of their life cycle. -The medically important parasites in this group are: Haemosporidia : Plasmodium Piroplasmidia: Coccidia: Babesia 1 -Toxoplasma 3 -Cryptosporidium 4 -Isospora 2 -Sarcocystis

Genus: Plasmodium Members of this genus are the cause of malaria. Species of plasmodia: 1 -Plasmodium vivax producing benign tertian malaria. It is widely spread in tropics and some temperate zones. It was found in Egypt. 2 - Plasmodium malariae producing quartan malaria. It is present in the tropics and subtropics. 3 -Plasmodium falciparum causing malignant subtertian malaria. It is distributed in the tropics and subtropics. It is called malignant because it is misleading in diagnosis. 4 -Plasmodium ovule causing ovale tertian malaria. It is confined mainly to the tropics.

Mode of infection 1 -Biological: By bite of female Anopheles mosquito. Infective stage is the sporozoite. 2 -Mechanical: Blood transfusion of an infected donor or among drug addicts. Infective stage is the schizont or merozoite. 3 -Congenital: This occurs through placental defects or during labor (connatal). Infective stage is the merozoite. Life cycle of Plasmodium: The life cycle of the parasite is completed in two different hosts. 1 -Asexual cycle "Schizogony" occurs in man. a) Pre- erythrocytic and exo- erythrocytic cycle in liver cells. b) Blood cycle or Erythrocytic cycle which takes place inside the RBCs

2 -Sexual cycle, "Gametogony" and "Sporogony" occur in the female Anopheles mosquito. Asexual cycle: (Schizogony) ) Pre-erythrocytic (exo-erythrocytic cycles): Infection of malaria done when infected female Anopheles bites a man, it injects the sporozoites into his blood (slender motile organisms). Sporozoites reach the liver cells to start a pre-erythrocytic cycle where they multiply producing schizonts, which lasts about 8 days. Rupture of schizonts release merozoites most of them invade quickly R. B. Cs. to begin the erythrocytic cycle.

In P. vivax and P. ovale some merozoites re-invade liver cells and differentiate into nonsexual hypnozoites that remain dormant for weeks, or even years. The activated hypnozoites undergo exo-erythrocytic schizogony, forming a wave of merozoites that cause a relapse. b)Erythrocytic cycle: Merozoites invade the red blood cells, where it grows and reproduces on the expense of the hemoglobin of the infected red blood cells. The developmental stages inside the RB. Cs. are: - Ring stage. - Trophozoite. - Schizont. - Gametocyte.


1 -Ring stage: Malarial parasite appears as a small rounded mass of cytoplasm with a single nucleus, and then a small vacuole rapidly develops inside the cytoplasm pushing the nucleus to one side, giving the parasite a ring shape. 2 -Trophozoite stage: The parasite shows a very active amoeboid movement with pseudopodia. Infected red cells are paler in color and in P. vivax they become larger in size. Pigment granules appear in the cytoplasm of the parasite known as hemozoin (malarial pigment).



3 -Schizont stage: Rounded in shape, Nuclear division by binary fission resulting in the formation of a large number of daughter nuclei, followed by division of the cytoplasm that collects around each nuclei leading to the formation of merozoites. Pigment granules tend to collect in the center of schizont. Shcizogony take a period of 48 h in P. vivax, P. ovale, 36 -48 h in P. falciparum, and 72 h in P. malariae. Infected red blood cell ruptures releasing merozoites and hemozoin pigment, which is the cause of the malarial paroxysm. Merozoites while circulating in the blood stream attack a new red blood cells and the cycle is repeated.

3 -Gametocyte stage: After repeated schizogony, some of the merozoites give rise to form gametocytes. Sexes are differentiated into male microgametocytes and female macrogametocytes. These stages do not cause any febrile reaction; they are responsible only for the continuation of the cycle in the mosquito. (2) Sexual cycle (Gametogony and Sporogony): 1 -Female Anopheles mosquito sucks up blood from a malarial patient. In the stomach of mosquito, all forms die except the gametocytes, which are transformed within few minutes into gametes (Gametogony).

2 -Male gametocyte (microgametocyte) develops by exflagellation through division of its nucleus into 4 -8 portions, each projects an actively moving filament and becomes a microgamete, which swim freely in the stomach contents. 3 -Female gametocyte (macrogametocyte) develops by nuclear reduction and becomes a macrogamete. Fertilization takes place between the male and female gametes resulting "zygote". Zygote elongates and becomes motile and is called "ookinete".

4 -Ookinete penetrates the epithelial cells lining the mucosa of mosquito's stomach and finally comes to rest just under the outer layer of the stomach wall. 5 -Ookinete become spherical in shape and surrounded by a cyst wall thus is called "oocyst". 6 -Oocyst increases in size, nucleus divides into a large number of nuclei each becomes surrounded by the cytoplasm, giving rise to slender bodies with pointed ends termed "sporocyst". 7 -Occyst (sporocyst) ruptures and the sporozoites reach the salivary glands of the mosquito. Infection to man is by the saliva injected by the mosquito during biting to prevent blood coagulation.


Clinical picture: In short malaria causing fever, rigors and anemia, with splenomegaly. Few days before patient may feel malaise, muscle pain, headache, and loss of appetite Diagnosis: 1 - Clinical picture: The characteristic paroxysms, pallor and enlarged tender spleen 2 - Blood examination: By thin and thick blood films stained with Giemsa or Leishman stains to demonstrate the erythrocytic stages. 3 - Serological tests: Fluorescent antibody test and ELISA 5 - PCR.

Prevention and control: 1 - Treatment of patients. 2 - Destruction of breeding places by draining ponds or by filling them with earth or by using larvicidal oil. 3 - The use of small fish (Gambusia) which eat mosquito larvae. 4 - The use of insecticides on the inner walls of houses to destroy adult mosquitoes. 5 - Screening of houses and the use of bed nets. 6 -Application of skin repellents over exposed areas of skin (citronella oil).
- Slides: 19